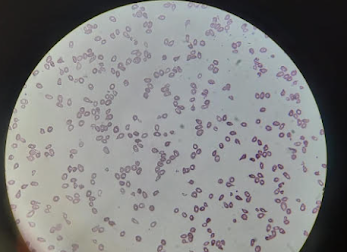

19 year old female with shortness of breath from the past 10 days
19-YEAR-OLD FEMALE PRESENTS WITH SHORTNESS OF BREATH FROM THE PAST 10 DAYS.
HISTORY OF PRESENTING ILLNESS
Patient was apparently asymptomatic
6 months ago, she experienced a heavier flow in menstrual bleeding, which has worsened in the last 3 months - where her cycles occur every 30 days and she bleeds for 5 days during which she has to use 10 -15 pads a day for the first 2 days.
She presented to the OB&G for the same and she was then referred to General Medicine.
From the past 10 days, the patient complains of shortness of breath on walking 4-5 steps, speaking, and even eating food associated with fatigue weakness palpitation, and sweating.
She complains of sudden breathlessness while in sleep that subsides when she takes a stroll in the greens for around 5 minutes - this has happened intermittently, and has occurred more in the last week. She also complains of slight difficulty in breathing while lying down-on being asked she says that it does not bother her so much.
On the day of admission - she complains of a severe episode of shortness of breath when she was packing to get to the hospital, which subsided when the ASHA worker near their apartment made her sleep to the side, opened the windows, and made her smell camphor.
PAST HISTORY
Patient was born to parents of a non-consanguineous marriage, through an FTNVD(Full Term Normal Vaginal Delivery) with a weight of 3.5 kg, was breastfed for 4 years, and immunized as per universal immunization schedule.
When the patient was
- 5 YEARS OLD - she came to the hospital with complaints of shortness of breath on walking, was transfused with 1 UNIT blood
- 10 YEARS OLD - SOB leading to difficulty in walking /playing; she was diagnosed with hypothyroidism and was started on 25ug of THYRONOM- dose was gradually increased to 75 ug, then to 150 ug and later decreased to 100ug over a period of time.
- 12 YEARS OLD - she was brought to the hospital because she was not growing in height and was obese. She was admitted to a hospital where bone marrow aspiration was done. The result is unknown as the documentation is lost. the patient was given Calcium, Iron, and Multivitamin Supplements which she took for two months, attained menopause 6 months later.
DRUG HISTORY
- Thyronorm
- Calcium, Iron, and Multivitamin supplements
PERSONAL HISTORY
- Diet- Mixed- prefers vegetarian food
- Appetite- Normal
- Sleep reduced from the past 10 days
- Bladder and bowel movements -Normal
- She has lost 5kgs of weight in the last month
- no history of fever, blood in stools,hematemesis
FAMILY HISTORY -
- Grandmother H/O thyroid issue
- No similar complaint in sibling who is 1.5 years older than her
MENSTRUAL HISTORY
- Attained menarche at 14 years of age
- 30/5 cycles
- Pain -present
- Clots - absent
- Uses 10-15 pads in the first 2 days of her period and then uses 2-3 pads/day in the remaining days.
GENERAL EXAMINATION -
- Patient is conscious coherent and cooperative and oriented to time, place, and person
- Pallor - Present
- Absence of icterus, cyanosis, lymphadenopathy, pedal edema, koilonychia
- BP- 90/60mmog Hg
- RR-24 cycles per minute
- PR- 80 breaths per minute
- diffuse enlargement of the thyroid gland
- JVP- raised
- Knuckles -Hyperpigmented.
- purpura- mild
RESPIRATORY SYSTEM EXAMINATION -
- Trachea - central in position
- BAE- present
- NVBS -heard
CARDIOVASCULAR SYSTEM EXAMINATION -
- S1, S2 heard
- No murmurs
- Carotid bruit - present
- Hyperdynamic apex
PER ABDOMEN EXAMINATION -
- Non-tender
- Grade 3 Splenomegaly (Spleen extended up to the umbilicus )
- Liver span - Dullness on percussion from 6th ICS to 3 cm from the right coastal margin
- bowel sounds heard
CNS EXAMINATION
- Higher mental functions - normal
- No focal neurological deposits
INVESTIGATIONS - DAY 1 -7/7/2021
1. Hemogram : (Morning
- HB- 4.5 gm/dl
- TC -2100 cells/cmm
- neutrophils -35 percent
- Lymphocytes -60 percent
- eosinophils-1 percent
- monocytes -4 percent
- basophils -0 percent
- PCV- 13.6 volume percent
- MCV- 129.5 fl
- MCH-42.9 pg
- MCHC- 42.9 percent
- RBC count -1.05 millions /cumm
- Platelet count -80,000 /cumm
- TSH - 61.33 micro lu/ml
- T3-82.84 ng/m
- T4-9.52 micro g/dl
3. Random Blood Sugar- 125 mg/dl
- APTT-30 seconds
- INR-1.0
5. LDH- 801 IU/L
6. LFT ;
- Total Bilirubin - 1.47 mg/dl
- Direct Bilirubin- 0.66mg/dl
- SGOT-58 IU/L
- SGPT -22IU/L
- ALP-85 IU/L
- TP-6.4 gm/dl
- Albumin -3.9 gm/dl
- A/G 1.6
11. PERIPHERAL BLOOD SMEAR - 7/7/21
RBC- Anisopoikilocytosis with microcytes, macrocytes, and teardrop cells
WBC - Reduced on smear with lymphocytosis
Platelet Count - reduced on smear
Pancytopenia
12. HEMOGRAM - 7/7/21(EVENING )
12. HEMOGRAM - 7/7/21(EVENING )
- HB- 4.1 gm/dl
- TC -1800cells/cmm
- neutrophils -25 percent
- Lymphocytes -70 percent
- eosinophils-1 percent
- monocytes -4 percent
- basophils -0 percent
- MCV- 129.0 fl
- MCH-44 pg
- MCHC- 34.2 percent
- RBC count -0.93 millions /cumm
- Platelet count -36000/cumm
- RDW-CV-23.3
- RDW-SD-94.9
13. Reticulocyte count - 0.7 percent

15. AHG(COOMBS TEST ) (8/7/2021)

16. BONE MARROW ASPIRATION AND PERIPHERAL BLOOD SMEAR - 4/4/14
The patient had slides of the bone marrow aspiration and peripheral Smear which was done when she was 12 years old, these were reviewed,
PROVISIONAL DIAGNOSIS -
Anemia under Evaluation
?Myelodysplastic Syndrome
?Aplastic anemia
TREATMENT PLAN -
Bone marrow Aspiration
TREATMENT 7/7/21 -4:00 PM
- Tab . THYRONORM 150 mg OD
- Tab. LASIX 40mg 1--0--1
TREATMENT - 8/7/21
- Tab . THYRONORM 150 mg OD
- Tab. LASIX 40mg 1--0--1
- Tab .OROFER XT BD 1--0--1
TREATMENT -11/7/2021
- Tab . THYRONORM 150 mg OD
- Tab. LASIX 20mg 1--0--1
- Tab.Regestrone 10mg 1-1-1
- Tab. PAUSE-MF 1-1-1
- Inj.VITCOFOL IM/BD 1ml(500mg)
TREATMENT - 12/7/21
- Tab . THYRONORM 150 mg OD
- Tab. LASIX 20mg 1--0--1
- Tab.Regestrone 10mg 1-1-1
- Inj.VITCOFOL IM/BD 1ml(500mg)
DISCHARGE SUMMARY
Diagnosis -
PANCYTOPENIA UNDER EVALUATION (/VITAMIN B12 DEFICIENCY /?HYPERSPLENISM)
MODERATE SPLEENOMEGAY
HYPOTHYROIDISM
MENORRHAGIA
ADVISE AT DISCHARGE
- TAB. THYRONORM 150MCG OD
- INJ. VITCOFOL (1ML = 500MCG) IM/BD FOR 5 DAYS F/B
- INJ. VITCOFOL (1ML=500MCG) IM/OD ON ALTERNATE DAYS FOR 1 WEEK F/B
- INJ. VITCOFOL (1ML=500MCG) OD ONCE IN A WEEK FOR 1 MONTH
- TAB. REGESTRONE 10MG TID FOR 3 DAYS
- F/B TAB. REGESTRONE 10MG BD FOR 5 DAYS
- F/B TAB. REGESTRONE 10MG OD FOR 5 DAYS.
- TAB. OROFER-XT OD FOR 1 MONTH.
- Regular Excercise
FOLLOW -UP
REVIEW AFTER ONE WEEK TO THE OBGYOPD
Case discussion :
Q. What are the causes of splenomegaly and what reasons do you think are the most likely cause for splenomegaly in this patient?
A. There are various causes of Splenomegaly including Liver cirrhosis, Splenic congestion, splenic sequestration, and acute or chronic infection cytopenias.
In our patient the most likely cause is pancytopenia.
Q. What is pancytopenia ? And what do we do to evaluate a case of pancytopenia ?
"Pancytopenia is a hematologic condition characterized by a decrease in all three peripheral blood cell lines."
Evaluation in a case of pancytopenia involves a complete blood picture, peripheral blood smear, and bone marrow aspirate cytology.

Comments
Post a Comment